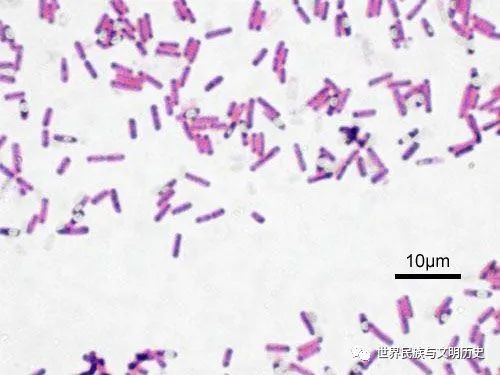

在人生的旅途中,我们时常会面临选择,尤其是在遭遇挫折、转换跑道或是追求新梦想时,“从头开始”与“重头开始”这两个词汇便悄然浮现,它们虽仅一字之差,却蕴含着截然不同的含义与深远的启示。本文将从心态、过程、目标设定、挑战应对及结果展望等多个维度,探讨这两者之间的微
在浩瀚的人生长河中,我们时常被那些不经意间飘入耳畔的旋律所打动,它们如同一盏盏明灯,照亮了我们内心的某个角落。今天,就让我们一起走进那首令人难以忘怀的歌曲——“茫茫人海中,有你有我”,揭开它背后的故事与情感,感受那份跨越时空的共鸣。旋律背后的故事这首歌曲,或许
揭秘“7x7x7x任意槽2023进口”:科技与生活的新交融点在2023年的科技浪潮中,一个令人瞩目的新词汇——“7x7x7x任意槽进口”悄然兴起,它不仅代表了进口商品的新风尚,更是科技与生活的完美融合,引领着新一轮的消费热潮。那么,这神秘的“7x7x7x任意槽
在这个快节奏、高效率的时代,人们在追求速度的同时,也越来越注重质量。尤其是在交友和婚恋领域,每个人都希望找到一个既安全又可靠的平台来帮助自己实现愿望。牵手网作为国内领先的婚恋交友平台,自成立以来一直致力于为用户提供真实、可靠、高质量的交友服务。那么,牵手网到底
在文学的浩瀚星空中,各种体裁如繁星点点,交相辉映,共同构成了人类精神世界的璀璨图景。其中,“万类霜天竞自由体裁”作为一种独特的文学现象,以其自由性、多元性和创新性,吸引了众多文学爱好者的目光。本文将带您深入探索这一体裁的内涵与特点,让您更全面地了解它的魅力所在
在这个充满挑战与机遇的世界里,人们追求快乐的方式多种多样。从日常生活的琐事到人生的重大决定,每个人都能找到让自己“高兴”的理由。本文旨在探讨“高兴的什么”、“高兴地什么”以及“高兴得什么”,以期帮助读者理解快乐的本质,并在自己的生活中寻找更多的快乐源泉。首先,
在英雄联盟(leagueoflegends,简称lol)的历史长河中,无数选手曾在这里留下了自己的印记。然而,随着时间的流逝,有些名字和他们的故事逐渐被人们所遗忘。今天,我们要讲述的是一个曾经闪耀过,但如今却少有人提及的名字——styz。styz,本名孙泰正,
5月28日出生的人属于双子座。双子座是黄道十二宫中的第三个星座,时间跨度为每年的5月21日至6月20日。因此,如果你是在5月28日出生,那么你就是一位典型的双子座人。双子座的人以其聪明、好奇和善于沟通而闻名。他们天生具有强烈的好奇心,喜欢探索新事物,并且总能在
 从头开始与重头开始的微妙差异,你选对了吗?
从头开始与重头开始的微妙差异,你选对了吗?
 人海茫茫,你我同在,这首歌触动心弦,你听过吗?
人海茫茫,你我同在,这首歌触动心弦,你听过吗?
 2023进口新奇迹:7x7x7超级矩阵与神秘任意槽技术融合!
2023进口新奇迹:7x7x7超级矩阵与神秘任意槽技术融合!
 牵手网的真实可靠性,你不可不知的秘密
牵手网的真实可靠性,你不可不知的秘密
霜天万象:自由竞逐的文学盛宴,解锁体裁新境
霜天万象:自由竞逐的文学盛宴,解锁体裁新境
 高兴成啥样?
高兴成啥样?
 LOL历史上的传奇选手:STYZ的辉煌与落寞
LOL历史上的传奇选手:STYZ的辉煌与落寞
 5月28日出生的星座查询
5月28日出生的星座查询